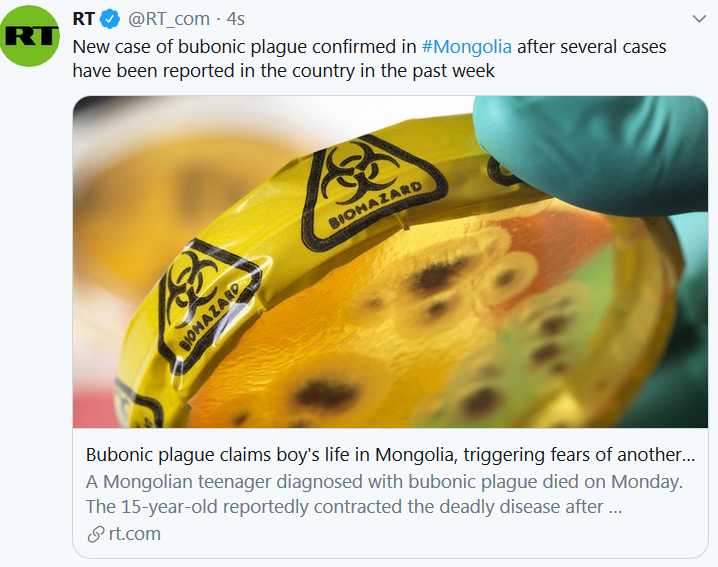

Descendants of Yeshuah Ben Yossef
- Yeshuah Ben Yossef was born 1 MAR in Bethléem and died in 33 in Jérusalem. He married Mariamne La Tour du
Troupeau (Migdal-Eder) Princesse de la Tribu de Be Migdal-eder in 26 in Tabgha, Galilée. Mariamne La Tour
du Troupeau (Migdal-Eder) Princesse de la Tribu de Be , daughter of Hérode I Le Grand Roi d’Israël,
Iduméen Le Grand and Mariamné Princesse de Benjamin, Nazaréenne Le Grand [Bat Ménahem] , was born
in Béthanie and died in 63 in Ste Beaume, Provence.
Children of Yeshuah Ben Yossef and Mariamne La Tour du Troupeau (Migdal-Eder) Princesse de la Tribu de Be Migdal-eder
i. 2. Sarah-Damaris Princesse de Juda pré-mérovingien [Bat Yeshuah] was born in 27 and died on an
unknown date.
ii. 3. Yeshuah-Joseph Yuz Asaf Jésus le cadet, Joseph Harama Théo du Graal Ben Yeshuah was born
in 33 in Judée and died in 120 in Srinagar, Cachemire
- Sarah-Damaris Princesse de Juda pré-mérovingien [Bat Yeshuah] was born in 27 and died on an unknown
date. She married Anthénor IV pré-mérovingien in 45. Anthénor IV, son of Clodomer III pré-mérovingien , was
born in 21 in Metz and died in 79.
Children of Sarah-Damaris Princesse de Juda pré-mérovingien [Bat Yeshuah] and Anthénor IV pré-mérovingien
i. 4. Rathérius pré-mérovingien was born in 45 in Metz and died on an unknown date. - Yeshuah-Joseph Yuz Asaf Jésus le cadet, Joseph Harama Théo du Graal Ben Yeshuah was born in 33 in
Judée and died in 120 in Srinagar, Cachemire. He married 1st Miss Ben Yeshuah [Bat Joseph] in 79 in Srinagar,
Cachemire. was born in 53 in Srinagar, Cachemire and died on an unknown date. He married 2nd
Mrs Ben Yeshuah[Yeshuah-Joseph] in 60 in Sarras.
an unknown date.
Children of Yeshuah-Joseph Yuz Asaf Jésus le cadet, Joseph Harama Théo du Graal Ben Yeshuah and Mrs Ben Yeshuah
[Yeshuah-Joseph]
i. 5. José Joséphé du Graal Faye was born in 61 and died on an unknown date.
ii. 6. Beatus Suetonius was born in Glastonbury, Angleterre and died in 96 in Helvétie, Suisse.
- Rathérius pré-mérovingien was born in 45 in Metz and died on an unknown date. He married Mrs pré-mérovingien
[Rathérius] in 70 in Metz. was born in 52 in Gaule and died on an unknown date.
Children of Rathérius pré-mérovingien and Mrs pré-mérovingien [Rathérius]
i. 7. Richymérus pré-mérovingien was born in 72 in Metz and died in 113. - José Joséphé du Graal Faye was born in 61 and died on an unknown date. He married Mrs Faye [José Faye] in
- was born in 90 and died on an unknown date.
Children of José Joséphé du Graal Faye and Mrs Faye [José Faye]
i. 8. Aminadab Roi pêcheur Ap Joshua was born in 109 in Trevan, Llanilid, Pays de Galles and died in Somme,
Picardie.
- Beatus Suetonius was born in Glastonbury, Angleterre and died in 96 in Helvétie, Suisse
- Richymérus pré-mérovingien was born in 72 in Metz and died in 113. He married Ascyla pré-mérovingien [des
- francs] in 87 in Metz. Ascyla was born in 80 and died on an unknown date.
- Children of Richymérus pré-mérovingien and Ascyla pré-mérovingien [des francs]
- i. 9. Odémar pré-mérovingien was born in 89 in Metz and died in 127.
- Aminadab Roi pêcheur Ap Joshua was born in 109 in Trevan, Llanilid, Pays de Galles and died in Somme, Picardie. He
- married Eurgen Reine de Septimanie Ap Joshua [de Cumbrie] in 154. Eurgen Reine de Septimanie, daughter
- of Lucius Roi Lucius, mawr d’ewyas and Gladys mawr d’ewyas [des Trinovantes], was born in 135 in Cumbrie
- and died on an unknown date.
- Children of Aminadab Roi pêcheur Ap Joshua and Eurgen Reine de Septimanie Ap Joshua [de Cumbrie]
- i. 10. Catheloys Narpus Roi Pêcheur was born in 155 and died on an unknown date.
- Odémar pré-mérovingien was born in 89 in Metz and died in 127. He married Mrs pré-mérovingien [Odémar] in
- 101 in Metz. was born in 80 in Gaule and died on an unknown date.
- Children of Odémar pré-mérovingien and Mrs pré-mérovingien [Odémar]
- i. 11. Marcomir IV pré-mérovingien was born in 103 in Metz and died in 152.
- Catheloys Narpus Roi Pêcheur was born in 155 and died on an unknown date. He married Mrs Roi Pêcheur
- [Catheloys] in 194. Mrs was born in 175 and died on an unknown date.
- Children of Catheloys Narpus Roi Pêcheur and Mrs Roi Pêcheur [Catheloys]
- i. 12. Manael Roi Pêcheur was born in 195 and died on an unknown da
- Marcomir IV pré-mérovingien was born in 103 in Metz and died in 152. He married Althildis Princesse de Juda
- pré-mérovingien in 120 in Metz. Althildis Princesse de Juda, daughter of Coel I Célidoine du Conte du Graal
- de Camu-Lot and Ystradwl de Camu-Lot [de Silurie], was born in 104 in Gaule celtique and died on an unknown date.
- Children of Marcomir IV pré-mérovingien and Althildis Princesse de Juda pré-mérovingien
- i. 13. Clodomir IV pré-mérovingien was born in 122 in Metz and died in 170.
- ii. 14. Marcomer pré-mérovingien was born in 124 in Metz and died on an unknown date.
- iii. 15. Clodion pré-mérovingien was born in 126 in Metz and died on an unknown date.
- iv. 16. Francus pré-mérovingien was born in 128 in Metz and died on an unknown date.
- v. 17. Derobacus pré-mérovingien was born in 130 in Metz and died on an unknown date.
- vi. 18. Nicanor pré-mérovingien was born in 132 in Metz and died on an unknown date.
- vii. 19. Odémarus pré-mérovingien was born in 134 in Metz and died on an unknown date.
- Manael Roi Pêcheur was born in 195 and died on an unknown date. He married Mrs Roi Pêcheur [Manael] in 234.
- was born in 215 and died on an unknown date.
- Children of Manael Roi Pêcheur and Mrs Roi Pêcheur [Manael]
- i. 20. Titurel Roi Pêcheur was born in 235 and died on an unknown date.
- Clodomir IV pré-mérovingien was born in 122 in Metz and died in 170. He married Basilde pré-mérovingien [de
- rugie] in 140 in Metz. Basilde was born in 126 and died on an unknown date.
- Children of Clodomir IV pré-mérovingien and Basilde pré-mérovingien [de rugie]
- i. 21. Farabertus pré-mérovingien was born in 142 in Metz and died in 190.
- Marcomer pré-mérovingien was born in 124 in Metz and died on an unknown date.
- Clodion pré-mérovingien was born in 126 in Metz and died on an unknown date.
- Francus pré-mérovingien was born in 128 in Metz and died on an unknown date.
- Mrs Roi Pêcheur [Manael]
- Derobacus pré-mérovingien was born in 130 in Metz and died on an unknown date.
- Nicanor pré-mérovingien was born in 132 in Metz and died on an unknown date.
- Odémarus pré-mérovingien was born in 134 in Metz and died on an unknown date.
- Titurel Roi Pêcheur was born in 235 and died on an unknown date. He married Mrs Roi Pêcheur [Titurel] in 274.
- was born in 256 and died on an unknown date.
- Children of Titurel Roi Pêcheur and Mrs Roi Pêcheur [Titurel]
- i. 22. Frimutel Roi Pêcheur was born in 275 and died on an unknown date
- Farabertus pré-mérovingien was born in 142 in Metz and died in 190. He married 1st (Unknown). He married 2nd
- (Unknown) in 161 in Metz.
- Children of Farabertus pré-mérovingien
- i. 23. Sunno pré-mérovingien was born in 163 in Metz and died in 207 in Metz.
- Frimutel Roi Pêcheur was born in 275 and died on an unknown date. He married Mrs Roi Pêcheur [Frimutel] in
- Mrs was born in 306 and died on an unknown date.
- Children of Frimutel Roi Pêcheur and Mrs Roi Pêcheur [Frimutel]
- i. 24. Boaz Anfortas Roi Pêcheur was born in 325 and died in 375
- Sunno pré-mérovingien was born in 163 in Metz and died in 207 in Metz. He married 1st (Unknown). He married 2nd
- (Unknown) in 178 in Metz.
- Children of Sunno pré-mérovingien
- i. 25. Hildéric pré-mérovingien was born in 180 in Metz and died in 232.
- Boaz Anfortas Roi Pêcheur was born in 325 and died in 375. He married mrs Roi Pêcheur [Boaz Anfortas] in
- mrs was born in 329 and died on an unknown date.
- Children of Boaz Anfortas Roi Pêcheur and mrs Roi Pêcheur [Boaz Anfortas]
- i. 26. Frotmund Roi Pêcheur was born in 355 and died on an unknown date.
- Hildéric pré-mérovingien was born in 180 in Metz and died in 232. He married 1st (Unknown). He married 2nd
- (Unknown).
- Children of Hildéric pré-mérovingien
- i. 27. Barthérus pré-mérovingien was born in 198 in Metz and died in 260.
- Frotmund Roi Pêcheur was born in 355 and died on an unknown date. He married Mrs Roi Pêcheur [Frotmund] in
- was born in 356 and died on an unknown date.
- Children of Frotmund Roi Pêcheur and Mrs Roi Pêcheur [Frotmund]
- i. 28. Pharamond Roi Pêcheur was born in 375 and died on an unknown date.
- Barthérus pré-mérovingien was born in 198 in Metz and died in 260. He married 1st (Unknown). He married 2nd
(Unknown) in 217 in Metz.
Children of Barthérus pré-mérovingien
i. 29. Clodius III pré-mérovingien was born in 219 in Metz and died in 287.
Mrs Roi Pêcheur [Frotmund] - Pharamond Roi Pêcheur was born in 375 and died on an unknown date. He married Mrs Roi Pêcheur
[Pharamond Roi Pêcheur] in 389 in Gaule armo. was born in 371 in Gaule armo and died on an unknown date.
Children of Pharamond Roi Pêcheur and Mrs Roi Pêcheur [Pharamond Roi Pêcheur]
i. 30. Frédémond Roi Pêcheur was born in 390 and died in Septimanie.
ii. 31. Frotmond was born in 392 and died in Septimanie - Clodius III pré-mérovingien was born in 219 in Metz and died in 287. He married 1st (Unknown). He married 2nd
- (Unknown) in 236 in Metz.
- Children of Clodius III pré-mérovingien
- i. 32. Obasther Walter pré-mérovingien was born in 238 and died in 310.
- Frédémond Roi Pêcheur was born in 390 and died in Septimanie. He married Mrs Roi Pêcheur [Frédémond].
- was born in 391 in Narbonne, Septimanie and died on an unknown date.
- Children of Frédémond Roi Pêcheur and Mrs Roi Pêcheur [Frédémond]
- i. 33. Nascien I Gondicaire de Burgondie de Septimanie was born in 410 in Narbonne, Septimanie and died on an
- unknown date.
- Frotmond was born in 392 and died in Septimanie. He married (Unknown).
- Obasther Walter pré-mérovingien was born in 238 and died in 310. He married 1st (Unknown). He married 2nd
- (Unknown) in 255 in Metz.
- Children of Obasther Walter pré-mérovingien
- i. 34. Dagobert I 1er du nom pré-mérovingien was born in 257 in Metz and died in 317.
- ii. 35. Clodomir V pré-mérovingien was born in 278 in Metz and died in 337.
- Mrs Roi Pêcheur
- Mrs Roi Pêcheur [Frédémond]
- Nascien I Gondicaire de Burgondie de Septimanie was born in 410 in Narbonne, Septimanie and died on an
- unknown date. He married Childéramna de Septimanie [de France] in 429 in Narbonne. Childéramna, daughter of
- Sunno de France and Mérowna de France [de thuringe], was born in 392 and died in 446.
- Children of Nascien I Gondicaire de Burgondie de Septimanie and Childéramna de Septimanie [de France]
- i. 36. Chlodion Gonderic Roi des Burgondes de Septimanie,de Burgondie was born in 430 in Septimanie
- and died in 472 in Septimanie
- Dagobert I 1er du nom pré-mérovingien was born in 257 in Metz and died in 317. He married (Unknown).
- Clodomir V pré-mérovingien was born in 278 in Metz and died in 337. He married 1st (Unknown). He married 2nd
- (Unknown) in 306 in Metz.
- Children of Clodomir V pré-mérovingien
- i. 37. Richimérus II pré-mérovingien was born in 308 in Metz and died in 350.
- Chlodion Gonderic Roi des Burgondes de Septimanie,de Burgondie was born in 430 in Septimanie and died
- in 472 in Septimanie. He married Caratène de Septimanie,de Burgondie [de suévie] in 432 in Septimanie. Caratène,
- daughter of Réchiaire de suévie and Né de suévie [d’amal], was born in 415 in Suévie and died in 506 in Suévie.
- Children of Chlodion Gonderic Roi des Burgondes de Septimanie,de Burgondie and Caratène de Septimanie,de Burgondie
- [de suévie]
- i. 38. Claffon Roi des lombards de Lombardie was born in 450 in Septimanie and died on an unknown date.
- ii. 39. Chilpéric II de Bourgogne was born in 455 and died in 492 in Lyon, Rhône.
- iii. 40. Godogisel Galains Thierry le prévôt dans la chanson de geste des Lor de genève was born in 457
- in Septimanie and died in 535 in Genève.
- iv. 41. Godobald Gondebaud IZambor des Burgondes de Septimanie de Burgondie was born in 459 in
- Septimanie and died in 516 in Lyon, Rhône.
- v. 42. Kriemhild des Burgondes was born in 461 in Septimanie and died on an unknown date.
- Richimérus II pré-mérovingien was born in 308 in Metz and died in 350. He married Bathilde Princesse
- d’Ephraïm pré-mérovingien [Fille du Roi de Saxonie] in 325. Bathilde Princesse d’Ephraïm was born in 310 in
- Saxonie and died on an unknown date.
- Children of Richimérus II pré-mérovingien and Bathilde Princesse d’Ephraïm pré-mérovingien [Fille du Roi de Saxonie]
- i. 43. Théodomir Roi des Francs et Prince d’Ephraïm pré-mérovingien was born in 326 and died in 360.
- Claffon Roi des lombards de Lombardie was born in 450 in Septimanie and died on an unknown date.
- Chilpéric II de Bourgogne was born in 455 and died in 492 in Lyon, Rhône. He married Agrippine de Bourgogne
- [de Narbonne] in 474 in France. Agrippine, daughter of Aggripin de Narbonne and Engeltrude de Narbonne
- [d’Orléans], was born in 455 and died in 506 in Lyon, Rhône.
- Children of Chilpéric II de Bourgogne and Agrippine de Bourgogne [de Narbonne]
- i. 44. Clothilde Ste Clothilde des Burgondes de france [de Bourgogne] was born in 475 in Burgondie and died
- on Jun. 3, 545 in Monastère St Martin, Tours, France.
- ii. 45. Willibald I de Bourgogne was born in 480 in France and died in 538 in France.
- Godogisel Galains Thierry le prévôt dans la chanson de geste des Lor de genève was born in 457 in
- Septimanie and died in 535 in Genève. He married 1st Eglise Duchesse Alice dans la chanson de geste des lorrai
- de genève [de Septimanie,de Lorraine] in 534 in Genève. Eglise Duchesse Alice dans la chanson de geste
- des lorrai, daughter of Wilibald Pellam Pierre Duc Pierre de Lorraine dans la Chanson de Geste de
- Septimanie,de Lorraine,de Burgondie, was born in 520 in Septimanie and died on an unknown date. He married 2nd
- Théodelinde de genève [de septimanie] in 487 in Septimanie. Théodelinde was born in 470 in Septimanie and died in
- 500 in Genève. He married 3rd Miss de genève [de Metz] in 519 in Metz. was born in 490 in Metz and died on an
- unknown date.
- Children of Godogisel Galains Thierry le prévôt dans la chanson de geste des Lor de genève and Eglise Duchesse Alice
- dans la chanson de geste des lorrai de genève [de Septimanie,de Lorraine]
- i. 46. Hervis Hervis de Metz dans la chanson de geste des lorrai de Metz,de Genève was born in 535 in
- Narbonne, Septimanie and died on an unknown date.
- Children of Godogisel Galains Thierry le prévôt dans la chanson de geste des Lor de genève and Théodelinde de genève
- [de septimanie]
- ii. 47. Joanan Jonaan dans le récit du Graal de Septimanie was born in 488 in Septimanie and died on an
- unknown date.
- iii. 48. Né Sédéleubeude de Bavière [de genève] was born in 490 in Genève and died on an unknown date.
- iv. 49. Florentinus de genève was born in 492 in Genève and died on an unknown date.
- Children of Godogisel Galains Thierry le prévôt dans la chanson de geste des Lor de genève and Miss de genève [de Metz]
- v. 50. Honorée de Metz was born in 520 in Metz and died on an unknown date.
- Godobald Gondebaud IZambor des Burgondes de Septimanie de Burgondie was born in 459 in Septimanie
- and died in 516 in Lyon, Rhône. He married Gontheuque de Septimanie de Burgondie [D’Ostrogothie].
- Gontheuque, daughter of Gonthier D’Ostrogothie, was born in 465 and died on an unknown date.
- Children of Godobald Gondebaud IZambor des Burgondes de Septimanie de Burgondie and Gontheuque de Septimanie de
- Burgondie [D’Ostrogothie]
- i. 51. Godomar Lambord de Septimanie was born in 480 in Septimanie and died in 532 in Septimanie.
- ii. 52. Sigismond II De Burgondie was born in 486 in Lyon, Rhône and died on Jun. 25, 524 in Isère, France.
- Kriemhild des Burgondes was born in 461 in Septimanie and died on an unknown date. She married 1st Warnachaire
- des burgondes in 499 in Burgondie. Warnachaire was born in 465 in Burgondie and died in 526 in Burgondie. She married
- 2nd Siegried Tueur de dragons Favnesbane. Siegried Tueur de dragons was born in 437 in Danemark and died in
- 480.Théodomir Roi des Francs et Prince d’Ephraïm pré-mérovingien was born in 326 and died in 360. He married
- 1st (Unknown). He married 2nd (Unknown) in 340.
- Children of Théodomir Roi des Francs et Prince d’Ephraïm pré-mérovingien
- i. 53. Clogio IV pré-mérovingien was born in 340 and died in 378.
- Clothilde Ste Clothilde des Burgondes de france [de Bourgogne] was born in 475 in Burgondie and died on
- Jun. 3, 545 in Monastère St Martin, Tours, France. She married Clovis I de france in 493. Clovis I, son of Childéric Ier
- de france and Basine de france [De Thuringe], was born in Aug. 466 in Tournai and died on Nov. 27, 511 in Paris, Seine.
- Children of Clothilde Ste Clothilde des Burgondes de france [de Bourgogne] and Clovis I de france
- i. 54. Clothaire I Le vieux de france was born in 497 and died on Nov. 10, 561.
- Willibald I de Bourgogne was born in 480 in France and died in 538 in France.
- Hervis Hervis de Metz dans la chanson de geste des lorrai de Metz,de Genève was born in 535 in
- Narbonne, Septimanie and died on an unknown date. He married Béatrix de Metz,de Genève [de Tyr] in 568 in Narbonne,
- Septimanie. Béatrix, daughter of Eustache Makir Ben Juda, Exilarque de Babylone d’aquitaine,Roi de Tyr and
- Mrs d’aquitaine,Roi de Tyr [de Tyr], was born in 553 and died on an unknown date.
- Children of Hervis Hervis de Metz dans la chanson de geste des lorrai de Metz,de Genève and Béatrix de Metz,de Genève
- [de Tyr]
- i. 55. Mara “amère” en hébreux duc de france,Duc de Genève [de genève] was born in 569 in Narbonne,
- Septimanie and died on an unknown date.
- ii. 56. Estha Héloïse Héloïse de Péviers dans la chanson de geste des Lo de Septimanie [de
- Genève,de Péviers] was born in 570 in Narbonne, Septimanie and died on an unknown date.
- iii. 57. Méora Béatrice Béatrice dans la chanson de geste des Lorrains “Astre” en de Galles [de
- genève] was born in 572 in Narbonne, Septimanie and died on an unknown date.
- iv. 58. Magdala Duc d’Alémanie [de genève] was born in 573 in Narbonne, Septimanie and died on an unknown date.
- v. 59. Bégon Bégue de Belin dans la chanson de geste des Lorrai de genève was born in 575 in Narbonne,
- Septimanie and died on an unknown date.
- vi. 60. Martha De Cambrai [de Genève] was born in 577 in Narbonne, Septimanie and died on an unknown date.
- vii. 61. Agloval de Genève was born in 579 in Narbonne and died on an unknown date.
- viii. 62. Né Ysaure Borelus [de genève] was born in 580 in Narbonne, Septimanie and died on an unknown date.
- ix. 63. Dandrane del acqs [de genève] was born in 583 in Narbonne, Septimanie and died in 600 in Pays de Galles,
- Grande Bre.
- x. 64. Garin le Loherain De Monglane was born in 585 in Narbonne, Septimanie and died in 635 in Metz.
- xi. 65. Hénée Hélène de Thurgovie [de genève] was born in 590 in Narbonne, Septimanie and died on an unknown
- date.
- Joanan Jonaan dans le récit du Graal de Septimanie was born in 488 in Septimanie and died on an unknown date.
- He married Fille de Maroneus de Septimanie . Fille de Maroneus was born in 490 in Gaule and died on an unknown date
- Né Sédéleubeude de Bavière [de genève] was born in 490 in Genève and died on an unknown date. She married
- Agiluf de Bavière. Agiluf was born in 490 and died on an unknown date.
- Children of Né Sédéleubeude de Bavière [de genève] and Agiluf de Bavière
- i. 66. Agivald de Bavière was born in 515 in Bavière and died on an unknown date.
- Florentinus de genève was born in 492 in Genève and died on an unknown date. He married Artnémia de genève
- [de lyon]. Artnémia was born in 490 in Lyon and died on an unknown date.
- Honorée de Metz was born in 520 in Metz and died on an unknown date. She married Baudri selon la chanson de
- geste des Lorrains in 536 in Metz. Baudri selon la chanson de geste des Lorrains was born in 515 in Metz and
- died on an unknown date.
- Godomar Lambord de Septimanie was born in 480 in Septimanie and died in 532 in Septimanie. He married 1st
- (Unknown). He married 2nd (Unknown).
- Children of Godomar Lambord de Septimanie
- i. 67. Wilibald Pellam Pierre Duc Pierre de Lorraine dans la Chanson de Geste de Septimanie,de
- Lorraine,de Burgondie was born in 500 in Septimanie and died on an unknown date.
- ii. 68. Taliesin le Barde was born in 532 in Septimanie and died in 599.
- Sigismond II De Burgondie was born in 486 in Lyon, Rhône and died on Jun. 25, 524 in Isère, France. He married
- Theudicote De Burgondie [D’Ostrogothie]. Theudicote was born in 475 and died in 521.
- Children of Sigismond II De Burgondie and Theudicote De Burgondie [D’Ostrogothie]
- i. 69. Suavégothe D’Austrasie [De Burgondie] was born in 504 in Lyon, Rhône and died in 554 in Metz, Moselle.
- Clogio IV pré-mérovingien was born in 340 and died in 378. He married Blésinde pré-mérovingien
- [d’Alémanie] in 353 in France. Blésinde, daughter of Chlodomer d’Alémanie, was born in 340 and died in 403 in France.
- Children of Clogio IV pré-mérovingien and Blésinde pré-mérovingien [d’Alémanie]
- i. 70. Marcomire V Roi des Francs pré-mérovingien was born in 353 in Metz and died in 393.
- ii. 71. Dagobert pré-mérovingien was born in 355 in Metz and died on an unknown date.
- iii. 72. Hector Prince d’Ephraïm Degembard was born in 357 and died on an unknown date.
- iv. 73. Diocles Roi des Francs Ripuaires du Nord de Cologne was born in 360 in France and died on an unknown
- date.
- Clothaire I Le vieux de france was born in 497 and died on Nov. 10, 561. He married Ingund de france [de
- Thuringe] in 561. Ingund, daughter of Chlodomir II De Worms and Arnégonde De Worms [De Saxe], was born in
- 510 and died in 536.
- Children of Clothaire I Le vieux de france and Ingund de france [de Thuringe]
- i. 74. Gonthaire de neustrie was born in 519 and died in 561 in Neustrie.
- ii. 75. Caribert I de Paris was born in 520 and died on May 7, 567 in Paris, Seine.
- iii. 76. Sigebert I de france was born in 535 and died in 575 in Austrasie.
- iv. 77. Chilpéric I de Neustrie was born in 537 and died on Oct. 1, 584 in Chelles.
- Mara “amère” en hébreux duc de france,Duc de Genève [de genève] was born in 569 in Narbonne,
- Septimanie and died on an unknown date. She married Geoffroy Basin Basin de Genève dans la chanson de geste
- des Lorra duc de france,Duc de Genève in 591. Geoffroy Basin Basin de Genève dans la chanson de
- geste des Lorra was born in 568 and died in 616.
- Estha Héloïse Héloïse de Péviers dans la chanson de geste des Lo de Septimanie [de Genève,de
- Péviers] was born in 570 in Narbonne, Septimanie and died on an unknown date. She married Elyezer de Septimanie in
- 584 in Narbonne. Elyezer, son of Aedalric Pelles de Septimanie and Richariane de Septimanie [de cambrai] ,
- was born in 560 in Septimanie and died on an unknown date.
- Méora Béatrice Béatrice dans la chanson de geste des Lorrains “Astre” en de Galles [de genève] was
- born in 572 in Narbonne, Septimanie and died on an unknown date. She married Rhun Doon le Chasseur, dans la
- chanson de geste des Lo de Galles in 586 in Pays de Ga. Rhun Doon le Chasseur, dans la chanson de
- geste des Lo was born in 550 in Pays de Ga and died on an unknown date.
- Magdala Duc d’Alémanie [de genève] was born in 573 in Narbonne, Septimanie and died on an unknown date. She
- married Selon la chanson de geste des Lorrains Duc d’Alémanie in 590. Selon la chanson de geste des
- Lorrains was born in 570 and died on an unknown date.
- Bégon Bégue de Belin dans la chanson de geste des Lorrai de genève was born in 575 in Narbonne,
- Septimanie and died on an unknown date. He married Mrs de genève [De Belin] in 600 in Narbonne, Septimanie.
- was born in 585 and died on an unknown date.
- Martha De Cambrai [de Genève] was born in 577 in Narbonne, Septimanie and died on an unknown date. She married
- selon la chanson de geste des Lorrains De Cambrai in 593 in Cambrai, Nord. selon la chanson de geste des
- Lorrains was born in 573 in Cambrai, Nord and died on an unknown date.
- Mrs de genève [De Belin]
- Agloval de Genève was born in 579 in Narbonne and died on an unknown date.
- Né Ysaure Borelus [de genève] was born in 580 in Narbonne, Septimanie and died on an unknown date. She married
- Jacob Hervis Filleul du Prévôt Thierry dans la chanson de geste Borelus in 598 in Narbonne, Septimanie.
- Jacob Hervis Filleul du Prévôt Thierry dans la chanson de geste was born in 580 in Narbonne, Septimanie and
- died on an unknown date.
- Dandrane del acqs [de genève] was born in 583 in Narbonne, Septimanie and died in 600 in Pays de Galles, Grande
- Bre. She married Galahad del acqs in 600 in Pays de Galles, Grande Bre. Galahad, son of Lancelot du Lac
- del Acqsand Elaine des Burgondes del Acqs [de Septimanie], was born in 583 in Septimanie and died in 608 in
- Sarras.
- Garin le Loherain De Monglane was born in 585 in Narbonne, Septimanie and died in 635 in Metz. He married Aélis
- De Monglane [de Lorraine] in 620 in Narbonne, Septimanie. Aélis was born in 604 and died on an unknown date.
- Children of Garin le Loherain De Monglane and Aélis De Monglane [de Lorraine]
- i. 78. Aelius Gracilis Gerbert Gerbert de Metz dans la chanson de ges te des lohengrin was born in 622
- in Narbonne, Septimanie and died in 734 in Narbonne, Septimanie.
- ii. 79. Ernand de Beaulande was born in 630 in Narbonne and died on an unknown date.
- Hénée Hélène de Thurgovie [de genève] was born in 590 in Narbonne, Septimanie and died on an unknown date.
- She married Bodilon Thierry Thierry le bandit, selon la chanson de geste des L de Thurgovie in 606.
- Bodilon Thierry Thierry le bandit, selon la chanson de geste des L was born in 590 and died on an unknown date.
- Agivald de Bavière was born in 515 in Bavière and died on an unknown date. He married 1st (Unknown). He married 2nd
- (Unknown) in 544 in Bavière.
- Children of Agivald de Bavière
- i. 80. Théodebald De Bavière was born in 545 in Souabie, Bavière and died on an unknown date.
- Wilibald Pellam Pierre Duc Pierre de Lorraine dans la Chanson de Geste de Septimanie,de
- Lorraine,de Burgondie was born in 500 in Septimanie and died on an unknown date. He married 1st (Unknown). He married
- 2nd (Unknown).
- Children of Wilibald Pellam Pierre Duc Pierre de Lorraine dans la Chanson de Geste de Septimanie,de Lorraine,de
- Burgondie
- i. 81. Eglise Duchesse Alice dans la chanson de geste des lorrai de genève [de Septimanie,de
- Lorraine] was born in 520 in Septimanie and died on an unknown date.
- ii. 82. Aedalric Pelles de Septimanie was born in 530 in Septimanie and died on an unknown date.
- Taliesin le Barde was born in 532 in Septimanie and died in 599. He married Viviane-Charis le Barde [d’Avallon
- del Acqs] in 544 in Septimanie. Viviane-Charis was born in 530 in Glastonbury, Sommerset and died in 560 in Septimanie.
- Suavégothe D’Austrasie [De Burgondie] was born in 504 in Lyon, Rhône and died in 554 in Metz, Moselle. She
- married Thierry I D’Austrasie. Thierry I, son of Clovis I de france and Amalaberge de france [Des Hérules],
- was born in 486 in Metz, Moselle and died in 534 in Metz, Moselle.
- Marcomire V Roi des Francs pré-mérovingien was born in 353 in Metz and died in 393. He married Hildegonde
- pré-mérovingien [de Lombardie] in 369 in Metz. Hildegonde, daughter of Richomer de toxandrie and Ascyla de
- toxandrie, was born in 375 and died in 425 in France.
- Children of Marcomire V Roi des Francs pré-mérovingien and Hildegonde pré-mérovingien [de Lombardie]
- i. 83. Pharamond Premier roi mérovingien pré-mérovingien was born in 371 and died in 428.
- ii. 84. Marcomir duc de France Orientale duc de france was born in 386 and died in 444.
- iii. 85. Hildegonde de cologne was born in 395 in Cologne and died in 450 in Cologne.
- Dagobert pré-mérovingien was born in 355 in Metz and died on an unknown date. He married 1st (Unknown). He
- married 2nd (Unknown).
- Children of Dagobert pré-mérovingien
- i. 86. Grénobaud duc de France Orientale duc de france was born in 372 in France Orientale and died on an
- unknown date.
- Hector Prince d’Ephraïm Degembard was born in 357 and died on an unknown date.
- Diocles Roi des Francs Ripuaires du Nord de Cologne was born in 360 in France and died on an unknown date.
- He married 1st (Unknown). He married 2nd (Unknown) in 380 in Allemagne.
- Children of Diocles Roi des Francs Ripuaires du Nord de Cologne
- i. 87. Blésinde de toxandrie [de cologne] was born in 375 in Cologne and died on an unknown date.
- Gonthaire de neustrie was born in 519 and died in 561 in Neustrie. He married (Unknown).
- Caribert I de Paris was born in 520 and died on May 7, 567 in Paris, Seine. He married Ingeberg de Paris [Des
- Francs]. Ingeberg was born in 519 in Paris, Seine and died in 589.
- Sigebert I de france was born in 535 and died in 575 in Austrasie. He married Brunehaut de france [des
- wisigoth]. Brunehaut was born in 537 and died in 613 in Austrasie.
- Chilpéric I de Neustrie was born in 537 and died on Oct. 1, 584 in Chelles. He married Frédégonde de Neustrie
- [d’Ardennes] in 568 in Paris, Seine. Frédégonde, daughter of Brunulphe Comte d’Ardennes d’Ardennes and
- Crotochielde d’Ardennes [d’Ostrogothie] , was born in 545 in Montdidier and died in 596 in Paris, Seine.
- Children of Chilpéric I de Neustrie and Frédégonde de Neustrie [d’Ardennes]
- i. 88. Clothaire II de france was born in Jun. 584 and died on Oct. 25, 628.
- Aelius Gracilis Gerbert Gerbert de Metz dans la chanson de ges te des lohengrin was born in 622 in
- Narbonne, Septimanie and died in 734 in Narbonne, Septimanie. He married Beatrix lohengrin [van Kleef] in 698 in
- Narbonne, Septimanie. Beatrix was born in 680 and died in 735.
- Ernand de Beaulande was born in 630 in Narbonne and died on an unknown date. He married (Unknown) in 679 in
- Narbonne.
- Théodebald De Bavière was born in 545 in Souabie, Bavière and died on an unknown date. He married 1st (Unknown).
- He married 2nd (Unknown) in 569.
- Children of Théodebald De Bavière
- i. 89. Gertrude de Burgondie [d’hamage] was born in 570 and died in Dec. 649.
- Eglise Duchesse Alice dans la chanson de geste des lorrai de genève [de Septimanie,de Lorraine]
- was born in 520 in Septimanie and died on an unknown date. She married Godogisel Galains Thierry le prévôt dans la
- chanson de geste des Lor de genève in 534 in Genève. Godogisel Galains Thierry le prévôt dans la
- chanson de geste des Lor, son of Chlodion Gonderic Roi des Burgondes de Septimanie,de Burgondie and
- Caratène de Septimanie,de Burgondie [de suévie] , was born in 457 in Septimanie and died in 535 in Genève.
Children of Eglise Duchesse Alice dans la chanson de geste des lorrai de genève [de Septimanie,de Lorraine] and
Godogisel Galains Thierry le prévôt dans la chanson de geste des Lor de genève
i. 46. Hervis Hervis de Metz dans la chanson de geste des lorrai de Metz,de Genève was born in 535 in
Narbonne, Septimanie and died on an unknown date.
- Aedalric Pelles de Septimanie was born in 530 in Septimanie and died on an unknown date. He married Richariane
de Septimanie [de cambrai]. Richariane, daughter of Richard II de cambrai, was born in 530 in Cambrai and died on
an unknown date.
Children of Aedalric Pelles de Septimanie and Richariane de Septimanie [de cambrai]
i. 90. Elyezer de Septimanie was born in 560 in Septimanie and died on an unknown date.
ii. 91. Althée de Burgondie was born in 560 in Bourgogne and died in 587 in Bourgogne.
iii. 92. Elaine des Burgondes del acqs [de Septimanie] was born in 565 in Septimanie and died Before 604 in
Septimanie - Pharamond Premier roi mérovingien pré-mérovingien was born in 371 and died in 428. He married Argotta
- pré-mérovingien [des Francs] in 405. Argotta, daughter of Grénobaud duc de France Orientale duc de
- france, was born in 390 in France Orientale and died on an unknown date.
- Children of Pharamond Premier roi mérovingien pré-mérovingien and Argotta pré-mérovingien [des Francs]
- i. 93. Clodion le Chevelu le chevelu Seigneur de Tournai Sgr de Tournai was born in 405 in Cambrai and
- died in 448 in Tournai.
- ii. 94. Erelieva d’Ostrogothie [De Tongres] was born in 410 and died on an unknown date.
- iii. 95. Cariatic De Morinie was born in 426 and died in 483.
- Marcomir duc de France Orientale duc de france was born in 386 and died in 444. He married (Unknown).
- Hildegonde de cologne was born in 395 in Cologne and died in 450 in Cologne. She married 1st Clodion le Chevelu
- le chevelu Seigneur de Tournai Sgr de Tournai in 435. Clodion le Chevelu le chevelu Seigneur de
- Tournai, son of Pharamond Premier roi mérovingien pré-mérovingien and Argotta pré-mérovingien [des
- Francs], was born in 405 in Cambrai and died in 448 in Tournai. She married 2nd Chlodion II Le Chevelu de france in
- 415 in Cologne. Chlodion II Le Chevelu, son of Thédomer de toxandrie and Blésinde de toxandrie [de
- cologne], was born in 392 in Cologne and died in 450 in Cologne.
- Children of Hildegonde de cologne and Clodion le Chevelu le chevelu Seigneur de Tournai Sgr de Tournai
- i. 96. Medelphus Louis Roi des Francs Ripuaires de Cologne De Thuringe was born in 415 in France and
- died on an unknown date.
- ii. 97. Mérovée des Francs was born in 420 and died in 458 in Tournai.
- iii. 98. Chlodomir Ieh De Worms was born in 425 in Worms and died on an unknown date.
- Children of Hildegonde de cologne and Chlodion II Le Chevelu de france
- iv. 99. Chlodwig de cologne was born in 410 in Cologne and died in 450 in Cologne.
- v. 100. Chlodeswinthe DE FRANCE was born in 418 in Cologne and died in 449.
- vi. 101. Chlodebaud de cologne was born in 420 in Cologne and died in 483 in Cologne.
- vii. 102. Landbert de thérouanne was born in 425 in Cologne and died in 459 in Boulogne.
- viii. 103. Ragnhard I de Cambrai was born in 430 in Cambrai and died in 467 in Cambrai.
- Grénobaud duc de France Orientale duc de france was born in 372 in France Orientale and died on an unknown
- date. He married 1st (Unknown). He married 2nd (Unknown).
- Children of Grénobaud duc de France Orientale duc de france
- i. 104. Argotta pré-mérovingien [des Francs] was born in 390 in France Orientale and died on an unknown date.
- Blésinde de toxandrie [de cologne] was born in 375 in Cologne and died on an unknown date. She married
- Thédomer de toxandrie. Thédomer, son of Richomer de toxandrie and Ascyla de toxandrie, was born in 374
- and died on Aug. 15, 414.
- Children of Blésinde de toxandrie [de cologne] and Thédomer de toxandrie
- i. 105. Chlodion II Le Chevelu de france was born in 392 in Cologne and died in 450 in Cologne.
- ii. 106. Blésinde de thérouanne was born in 400 and died on an unknown date.
- Clothaire II de france was born in Jun. 584 and died on Oct. 25, 628. He married 1st Bérétrude de france [de
- Burgondie] in 604. Bérétrude, daughter of Richomer de Burgondie and Gertrude de Burgondie [d’hamage],
- was born in 590 and died in 618. He married 2nd Hadeltrude de france [D’Austrasie]. Hadeltrude was born in 585 and
- died in 604 in Rouen, Normandie.
- Children of Clothaire II de france and Bérétrude de france [de Burgondie]
- i. 107. Dagobert I Roi d’Austrasie et Roi des Francs de france was born in 602 and died in 639.
- ii. 108. Charibert II Roi de Toulouse et d’Aquitaine de Toulouse was born in 608 and died in 631 in Toulouse,
- Septimanie.
- Children of Clothaire II de france and Hadeltrude de france [D’Austrasie]
- iii. 109. De Mercie [De Neustrie] was born in 600 and died in 622.
- iv. 110. Emma De Kent [De Neustrie] was born in 603 and died on an unknown date.
- Gertrude de Burgondie [d’hamage] was born in 570 and died in Dec. 649. She married Richomer de Burgondie
- in 589. Richomer, son of Betton de Burgondie and Austregilde de Burgondie [D’Orléans], was born in 555 and
- died on an unknown date.
- Children of Gertrude de Burgondie [d’hamage] and Richomer de Burgondie
- i. 111. Bérétrude de france [de Burgondie] was born in 590 and died in 618.
- Hervis Hervis de Metz dans la chanson de geste des lorrai de Metz,de Genève was born in 535 in
- Narbonne, Septimanie and died on an unknown date.
- See previous entry for Hervis Hervis de Metz dans la chanson de geste des lorrai de Metz,de Genève was born
- in 535 in Narbonne, Septimanie and died on an unknown date.
- Elyezer de Septimanie was born in 560 in Septimanie and died on an unknown date. He married Estha Héloïse
- Héloïse de Péviers dans la chanson de geste des Lo de Septimanie [de Genève,de Péviers] in 584 in
- Narbonne. Estha Héloïse Héloïse de Péviers dans la chanson de geste des Lo , daughter of Hervis Hervis de
- Metz dans la chanson de geste des lorrai de Metz,de Genève and Béatrix de Metz,de Genève [de Tyr],
- was born in 570 in Narbonne, Septimanie and died on an unknown date.
- Althée de Burgondie was born in 560 in Bourgogne and died in 587 in Bourgogne. He married Theudelinde de
- Burgondie [de bavière] in 582 in Bourgogne. Theudelinde was born in 567 and died in 627.
- Children of Althée de Burgondie and Theudelinde de Burgondie [de bavière]
- i. 112. guillebaud II des Burgondes was born in 585 and died in 642 in Septimanie.
- ii. 113. Hymnéchilde De Gothie [Des Burgondes] was born in 587 in Bourgogne and died on an unknown date.
- Elaine des Burgondes del acqs [de Septimanie] was born in 565 in Septimanie and died Before 604 in Septimanie.
- She married Lancelot du Lac del Acqs in 582 in Septimanie. Lancelot was born in 560 in Septimanie and died on an unknown date.
- Children of Elaine des Burgondes del acqs [de Septimanie] and Lancelot du Lac del Acqs
- i. 114. Galahad del acqs was born in 583 in Septimanie and died in 608 in Sarras
- Clodion le Chevelu Seigneur de Tournai was born in 405 in Cambrai and died in 448 in Tournai. He married
- Hildegonde de cologne in 435. Hildegonde, daughter of Marcomire V Roi des Francs
- pré-mérovingien and Hildegonde pré-mérovingien [de Lombardie] , was born in 395 in Cologne and died in 450 in
- Cologne.
- Children of Clodion le Chevelu Seigneur de Tournai and Hildegonde de cologne
- i. 96. Medelphus Louis Roi des Francs Ripuaires de Cologne De Thuringe was born in 415 in France and
- died on an unknown date.
- ii. 97. Mérovée des Francs was born in 420 and died in 458 in Tournai.
- iii. 98. Chlodomir Ieh De Worms was born in 425 in Worms and died on an unknown date.
- Erelieva d’Ostrogothie [De Tongres] was born in 410 and died on an unknown date. She married Théodemir
- d’Ostrogothie in 454. Théodemir, son of Winithar d’Ostrogothie, died in 472.
- Children of Erelieva d’Ostrogothie [De Tongres] and Théodemir d’Ostrogothie
- i. 115. Théoderic I Le Grand Roi des Ostrogoths d’Italie d’Ostrogothie was born in 455 and died on Aug. 30,
- 526 in Ravenne.
- ii. 116. Argotte De Ponthieu [D’Ostrogothie] was born in 460 and died on an unknown date.
- iii. 117. Amalafriede d’Ostrogothie was born in 462 and died on an unknown date.
- Cariatic De Morinie was born in 426 and died in 483. He married 1st (Unknown). He married 2nd (Unknown).
- Children of Cariatic De Morinie
- i. 118. Clotonde Princesse des Morins De Worms [De Morinie] was born in 460 and died in 510.
- Medelphus Louis Roi des Francs Ripuaires de Cologne De Thuringe was born in 415 in France and died on
- an unknown date. He married Basine De Thuringe [de Saxe]. Basine, daughter of Widelphe de Saxe and
- Amalberge de Saxe [d’Ostrogothie] , was born in 408 in Allemagne and died in 476 in Allemagne.
- Children of Medelphus Louis Roi des Francs Ripuaires de Cologne De Thuringe and Basine De Thuringe [de Saxe]
- i. 119. Basine de france [De Thuringe] was born in 438 and died on an unknown date.
- Mérovée des Francs was born in 420 and died in 458 in Tournai. He married Mériva des Francs in 435. Mériva was
- born in 420 and died on an unknown date.
- Children of Mérovée des Francs and Mériva des Francs
- i. 120. Childéric Ier de france was born in 436 in Tournai and died in 481 in Tournai.
- Chlodomir Ieh De Worms was born in 425 in Worms and died on an unknown date. He married Afgandestria De
- Worms [Afgandestrius]. Afgandestria, daughter of Pogatius Afgandestrius, was born in 425 in Rome and died in
- 460.
- Children of Chlodomir Ieh De Worms and Afgandestria De Worms [Afgandestrius]
- i. 121. Chlodoric Ier De Worms was born in 460 in Worms and died on an unknown date.
- Chlodwig de cologne was born in 410 in Cologne and died in 450 in Cologne.
- Chlodeswinthe DE FRANCE was born in 418 in Cologne and died in 449.
- Chlodebaud de cologne was born in 420 in Cologne and died in 483 in Cologne. He married Amalaberge de
- cologne [de france]. Amalaberge was born in 435 and died in 478.
- Children of Chlodebaud de cologne and Amalaberge de cologne [de france]
- i. 122. Sigemer de cologne was born in 450 in Cologne and died on an unknown date.
- ii. 123. Sigebert de cologne was born in 455 in Cologne and died in 509 in Cologne.
- iii. 124. Albéric De Ponthieu was born in 460 and died in 525.
- iv. 125. Adalbert de moselle died in 491 in Moselle.
- Landbert de thérouanne was born in 425 in Cologne and died in 459 in Boulogne.
- Ragnhard I de Cambrai was born in 430 in Cambrai and died in 467 in Cambrai. He married 1st (Unknown). He married
- 2nd (Unknown).
- Children of Ragnhard I de Cambrai
- i. 126. Richard d’arras died in 512 in Le Mans.
- ii. 127. Ragnhard II de Cambrai died in 508 in Cambrai.
- Argotta pré-mérovingien [des Francs] was born in 390 in France Orientale and died on an unknown date. She
- married Pharamond Premier roi mérovingien pré-mérovingien in 405. Pharamond Premier roi mérovingien ,
- son of Marcomire V Roi des Francs pré-mérovingien and Hildegonde pré-mérovingien [de Lombardie] , was
- born in 371 and died in 428.
- Children of Argotta pré-mérovingien [des Francs] and Pharamond Premier roi mérovingien pré-mérovingien
- i. 93. Clodion le Chevelu le chevelu Seigneur de Tournai Sgr de Tournai was born in 405 in Cambrai and
- died in 448 in Tournai.
- ii. 94. Erelieva d’Ostrogothie [De Tongres] was born in 410 and died on an unknown date.
- iii. 95. Cariatic De Morinie was born in 426 and died in 483.
- Chlodion II Le Chevelu de france was born in 392 in Cologne and died in 450 in Cologne. He married Hildegonde
- de cologne in 415 in Cologne. Hildegonde, daughter of Marcomire V Roi des Francs pré-mérovingien and
- Hildegonde pré-mérovingien [de Lombardie] , was born in 395 in Cologne and died in 450 in Cologne.
- Children of Chlodion II Le Chevelu de france and Hildegonde de cologne
- i. 99. Chlodwig de cologne was born in 410 in Cologne and died in 450 in Cologne.
- ii. 100. Chlodeswinthe DE FRANCE was born in 418 in Cologne and died in 449.
- iii. 101. Chlodebaud de cologne was born in 420 in Cologne and died in 483 in Cologne.
- iv. 102. Landbert de thérouanne was born in 425 in Cologne and died in 459 in Boulogne.
- v. 103. Ragnhard I de Cambrai was born in 430 in Cambrai and died in 467 in Cambrai.
- Blésinde de thérouanne was born in 400 and died on an unknown date.
- Dagobert I Roi d’Austrasie et Roi des Francs de france was born in 602 and died in 639. He married 1st
- Nantilde de france. He married 2nd Bertrude de france in 650. He married 3rd Ragentrude de france
- [d’Ardennes]. Ragentrude was born in 610 in France and died in 632 in France.
- Children of Dagobert I Roi d’Austrasie et Roi des Francs de france and Nantilde de france
- i. 128. Clovis II de Neustrie was born in 633 in France and died in 657 in France.
Children of Dagobert I Roi d’Austrasie et Roi des Francs de france and Bertrude de france
ii. 129. Sigisbert III Roi d’Austrasie de france died in 656.
Children of Dagobert I Roi d’Austrasie et Roi des Francs de france and Ragentrude de france [d’Ardennes]
iii. 130. Réginotrude de Francie was born in 623 in Bavière and died on an unknown date.
iv. 131. Ragendrude d’Oeren [de Neustrie] was born in 632 in France and died on an unknown date.
- Charibert II Roi de Toulouse et d’Aquitaine de Toulouse was born in 608 and died in 631 in Toulouse,
Septimanie. He married (Unknown). - De Mercie [De Neustrie] was born in 600 and died in 622. She married Wibba De Mercie. Wibba was born in 560
and died in 615. - Emma De Kent [De Neustrie] was born in 603 and died on an unknown date. She married Eadbald De Kent .
Eadbald was born in 570 in Kent and died on Jan. 20, 640. - Bérétrude de france [de Burgondie] was born in 590 and died in 618. She married Clothaire II de france in 604.
Clothaire II, son of Chilpéric I de Neustrie and Frédégonde de Neustrie [d’Ardennes], was born in Jun. 584 and
died on Oct. 25, 628.
Children of Bérétrude de france [de Burgondie] and Clothaire II de france
i. 107. Dagobert I Roi d’Austrasie et Roi des Francs de france was born in 602 and died in 639.
ii. 108. Charibert II Roi de Toulouse et d’Aquitaine de Toulouse was born in 608 and died in 631 in Toulouse,
Septimanie. - Guillebaud II des Burgondes was born in 585 and died in 642 in Septimanie. He married Leudegonde des
Burgondes [de frioul]. Leudegonde was born in 590 in Septimanie and died on an unknown date.
Children of Guillebaud II des Burgondes and Leudegonde des Burgondes [de frioul]
i. 132. Né des Burgondes was born in 625 in Septimanie and died on an unknown date.
ii. 133. Immichilde de france [des Burgondes] was born in 633 in Septimanie and died in 670. - Hymnéchilde De Gothie [Des Burgondes] was born in 587 in Bourgogne and died on an unknown date. She
married Agnéric De Gothie. Agnéric was born in 595 and died in 628 - Galahad del acqs was born in 583 in Septimanie and died in 608 in Sarras. He married Dandrane del acqs [de
- genève] in 600 in Pays de Galles, Grande Bre. Dandrane, daughter of Hervis Hervis de Metz dans la chanson de
- geste des lorrai de Metz,de Genève and Béatrix de Metz,de Genève [de Tyr], was born in 583 in Narbonne,
- Septimanie and died in 600 in Pays de Galles, Grande Bre.
- Medelphus Louis Roi des Francs Ripuaires de Cologne De Thuringe was born in 415 in France and died on
- an unknown date.
- See previous entry for Medelphus Louis Roi des Francs Ripuaires de Cologne De Thuringe was born in 415 in
- France and died on an unknown date.
- Mérovée des Francs was born in 420 and died in 458 in Tournai.
- See previous entry for Mérovée des Francs was born in 420 and died in 458 in Tournai.
- Chlodomir Ieh De Worms was born in 425 in Worms and died on an unknown date.
- See previous entry for Chlodomir Ieh De Worms was born in 425 in Worms and died on an unknown date.
- Théoderic I Le Grand Roi des Ostrogoths d’Italie d’Ostrogothie was born in 455 and died on Aug. 30, 526 in
- Ravenne. He married 1st Audoflède d’Ostrogothie [de Francie]in 492. Audoflède, daughter of Childéric Ier de
- france and Basine de france [De Thuringe], was born in 469 and died on May 4, 535. He married 2nd Princesse
- d’Ostrogothie [DES HUNS]. Princesse was born in 460 in Pannonie, Hongrie and died on an unknown date.
- Children of Théoderic I Le Grand Roi des Ostrogoths d’Italie d’Ostrogothie and Audoflède d’Ostrogothie [de Francie]
- i. 134. Amalasunte Régente d’Italie d’Ostrogothie was born in 535 in Bolsena and died on an unknown date.
- Children of Théoderic I Le Grand Roi des Ostrogoths d’Italie d’Ostrogothie and Princesse d’Ostrogothie [DES HUNS]
- ii. 135. Theudicote Des Wisigoths [D’OSTROGOTHIE] was born About 475 and died About 521.
- Argotte De Ponthieu [D’Ostrogothie] was born in 460 and died on an unknown date. She married Albéric De
- Ponthieu. Albéric, son of Chlodebaud de cologne and Amalaberge de cologne [de france] , was born in 460 and
- died in 525.
- Children of Argotte De Ponthieu [D’Ostrogothie] and Albéric De Ponthieu
- i. 136. Wautbert Ier, Comte DE PONTHIEU was born About 490 and died About 538.
- ii. 137. Gertrude DE PONTHIEU was born About 500 and died on an unknown date.
- Amalafriede d’Ostrogothie was born in 462 and died on an unknown date.
- Clotonde Princesse des Morins De Worms [De Morinie] was born in 460 and died in 510. She married
- Chlodoric Ier De Worms. Chlodoric Ier, son of Chlodomir Ieh De Worms and Afgandestria De Worms
- [Afgandestrius], was born in 460 in Worms and died on an unknown date.
- Children of Clotonde Princesse des Morins De Worms [De Morinie] and Chlodoric Ier De Worms
- i. 138. Chlodomir II De Worms was born in 490 and died in 532
- Basine de france [De Thuringe] was born in 438 and died on an unknown date. She married Childéric Ier de
- france in 466 in Tournai. Childéric Ier, son of Mérovée des Francs and Mériva des Francs, was born in 436 in
- Tournai and died in 481 in Tournai.
- Children of Basine de france [De Thuringe] and Childéric Ier de france
- i. 139. Clovis I de france was born in Aug. 466 in Tournai and died on Nov. 27, 511 in Paris, Seine.
- ii. 140. Audoflède d’Ostrogothie [de Francie] was born in 469 and died on May 4, 535.
- Childéric Ier de france was born in 436 in Tournai and died in 481 in Tournai. He married Basine de france [De
- Thuringe] in 466 in Tournai. Basine, daughter of Medelphus Louis Roi des Francs Ripuaires de Cologne De
- Thuringe and Basine De Thuringe [de Saxe], was born in 438 and died on an unknown date.
- Children of Childéric Ier de france and Basine de france [De Thuringe]
- i. 139. Clovis I de france was born in Aug. 466 in Tournai and died on Nov. 27, 511 in Paris, Seine.
- ii. 140. Audoflède d’Ostrogothie [de Francie] was born in 469 and died on May 4, 535.
- Chlodoric Ier De Worms was born in 460 in Worms and died on an unknown date. He married Clotonde Princesse
- des Morins De Worms [De Morinie] . Clotonde Princesse des Morins, daughter of Cariatic De Morinie, was
- born in 460 and died in 510.
- Children of Chlodoric Ier De Worms and Clotonde Princesse des Morins De Worms [De Morinie]
- i. 138. Chlodomir II De Worms was born in 490 and died in 532.
- Sigemer de cologne was born in 450 in Cologne and died on an unknown date.
- Sigebert de cologne was born in 455 in Cologne and died in 509 in Cologne. He married Théodelinde de cologne
- [des burgondes] in 479 in Cologne. Théodelinde was born in 460 in Septimanie and died on an unknown date.
- Albéric De Ponthieu was born in 460 and died in 525. He married Argotte De Ponthieu [D’Ostrogothie].
- Argotte, daughter of Théodemir d’Ostrogothie and Erelieva d’Ostrogothie [De Tongres], was born in 460 and
- died on an unknown date.
- Children of Albéric De Ponthieu and Argotte De Ponthieu [D’Ostrogothie]
- i. 136. Wautbert Ier, Comte DE PONTHIEU was born About 490 and died About 538.
- ii. 137. Gertrude DE PONTHIEU was born About 500 and died on an unknown date.
- Adalbert de moselle died in 491 in Moselle.
- Richard d’arras died in 512 in Le Mans. He married 1st (Unknown). He married 2nd (Unknown).
- Children of Richard d’arras
- i. 141. Richard II de cambrai was born in 510 in Artois and died on an unknown date.
- Ragnhard II de Cambrai died in 508 in Cambrai. He married 1st (Unknown). He married 2nd (Unknown).
- Children of Ragnhard II de Cambrai
- i. 142. Ricmer II de Cambrai died in 528.
- Clodion le Chevelu le chevelu Seigneur de Tournai Sgr de Tournai was born in 405 in Cambrai and died in
- 448 in Tournai.
- See previous entry for Clodion le Chevelu le chevelu Seigneur de Tournai Sgr de Tournai was born in 405 in
- Cambrai and died in 448 in Tournai.
- Erelieva d’Ostrogothie [De Tongres] was born in 410 and died on an unknown date.
- See previous entry for Erelieva d’Ostrogothie [De Tongres] was born in 410 and died on an unknown date.
- Cariatic De Morinie was born in 426 and died in 483.
- See previous entry for Cariatic De Morinie was born in 426 and died in 483.
- Chlodwig de cologne was born in 410 in Cologne and died in 450 in Cologne.
- See previous entry for Chlodwig de cologne was born in 410 in Cologne and died in 450 in Cologne.
- Chlodeswinthe DE FRANCE was born in 418 in Cologne and died in 449.
- See previous entry for Chlodeswinthe DE FRANCE was born in 418 in Cologne and died in 449.
- Chlodebaud de cologne was born in 420 in Cologne and died in 483 in Cologne.
- See previous entry for Chlodebaud de cologne was born in 420 in Cologne and died in 483 in Cologne.
- Landbert de thérouanne was born in 425 in Cologne and died in 459 in Boulogne.
- See previous entry for Landbert de thérouanne was born in 425 in Cologne and died in 459 in Boulogne.
- Ragnhard I de Cambrai was born in 430 in Cambrai and died in 467 in Cambrai.
- See previous entry for Ragnhard I de Cambrai was born in 430 in Cambrai and died in 467 in Cambrai.
- Clovis II de Neustrie was born in 633 in France and died in 657 in France. He married Bathilde de Neustrie
- [D’Ascanie] in 650. Bathilde was born in 635 in Cloyne, Irlande and died on Jan. 1, 680 in Chelles, France.
- Children of Clovis II de Neustrie and Bathilde de Neustrie [D’Ascanie]
- i. 143. Childéric II de france was born in 651 and died in 674.
- Sigisbert III Roi d’Austrasie de france died in 656. He married Immichilde de france [des Burgondes]in
- Immichilde, daughter of Guillebaud II des Burgondes and Leudegonde des Burgondes [de frioul], was
- born in 633 in Septimanie and died in 670.
- Children of Sigisbert III Roi d’Austrasie de france and Immichilde de france [des Burgondes]
- i. 144. Dagobert II Roi d’Austrasie de france was born in 651 and died in 679.
- ii. 145. Berswinthe d’Alsace [de Bourgogne] was born in 653 in Bourgogne and died in 690 in Alsace.
- iii. 146. Blichilde de france was born in 655 and died on an unknown date.
- Réginotrude de Francie was born in 623 in Bavière and died on an unknown date. She married 1st Robert III Cte
- palatin 678, référendaire de Childéric II, mai de Wormsgau in 619. Robert III Cte palatin 678, référendaire
- de Childéric II, mai was born in 610 and died in 693 in Paris, Seine. She married 2nd Théodon VII de Bavière in 635.
- Théodon VII was born in 615 in Bavière and died in 680 in Bavière.
- Ragendrude d’Oeren [de Neustrie] was born in 632 in France and died on an unknown date. She married
- Théodard d’Oeren in 648 in Flandre. Théodard was born in 620 and died in 673 in Flandre.
- Dagobert I Roi d’Austrasie et Roi des Francs de france was born in 602 and died in 639.
- See previous entry for Dagobert I Roi d’Austrasie et Roi des Francs de france was born in 602 and died in 639.
- Charibert II Roi de Toulouse et d’Aquitaine de Toulouse was born in 608 and died in 631 in Toulouse,
- Septimanie.
- See previous entry for Charibert II Roi de Toulouse et d’Aquitaine de Toulouse was born in 608 and died in 631 in
- Toulouse, Septimanie.
- Né des Burgondes was born in 625 in Septimanie and died on an unknown date.
- Immichilde de france [des Burgondes] was born in 633 in Septimanie and died in 670. She married Sigisbert III
- Roi d’Austrasie de france in 650. Sigisbert III Roi d’Austrasie , son of Dagobert I Roi d’Austrasie et Roi des
- Francs de france and Bertrude de france, died in 656.
- Children of Immichilde de france [des Burgondes] and Sigisbert III Roi d’Austrasie de france
- i. 144. Dagobert II Roi d’Austrasie de france was born in 651 and died in 679.
- ii. 145. Berswinthe d’Alsace [de Bourgogne] was born in 653 in Bourgogne and died in 690 in Alsace.
- iii. 146. Blichilde de france was born in 655 and died on an unknown date.
- Amalasunte Régente d’Italie d’Ostrogothie was born in 535 in Bolsena and died on an unknown date. She married
- Uthéric d’Ostrogothie in 525. Uthéric, son of Widéric d’Ostrogothie, was born in 490 and died in 524.
- Children of Amalasunte Régente d’Italie d’Ostrogothie and Uthéric d’Ostrogothie
- i. 147. Crotochielde d’Ardennes [d’Ostrogothie] was born in 526 and died on an unknown date.
- Theudicote Des Wisigoths [D’OSTROGOTHIE] was born About 475 and died About 521. She married Alaric II
- Des Wisigoths. Alaric II was born in 458 in Toulouse, Languedoc and died in 507 in Vouill é, Vienne.
- Wautbert Ier, Comte DE PONTHIEU was born About 490 and died About 538. He married Lucile DE PONTHIEU
- [D’ORIENT] About 515. Lucile, daughter of Zénon II D’ISAURIE, was born About 490 in Pannonie, Hongrie and died on an
- unknown date.
- Children of Wautbert Ier, Comte DE PONTHIEU and Lucile DE PONTHIEU [D’ORIENT]
- i. 148. Waubert II, Comte DE HAINAUT was born About 520 and died About 575.
- ii. 149. Brunulphe Comte d’Ardennes d’Ardennes was born in 522 in Ardennes and died in 563 in Ardennes.
- Gertrude DE PONTHIEU was born About 500 and died on an unknown date.
- Chlodomir II De Worms was born in 490 and died in 532. He married Arnégonde De Worms [De Saxe].
- Arnégonde, daughter of Virich De Saxe, was born in 490 in Saxe and died on an unknown date.
- Children of Chlodomir II De Worms and Arnégonde De Worms [De Saxe]
- i. 150. Ingund de france [de Thuringe] was born in 510 and died in 536.
- Clovis I de france was born in Aug. 466 in Tournai and died on Nov. 27, 511 in Paris, Seine. He married 1st Clothilde
- Ste Clothilde des Burgondes de france [de Bourgogne] in 493. Clothilde Ste Clothilde des Burgondes,
- daughter of Chilpéric II de Bourgogne and Agrippine de Bourgogne [de Narbonne], was born in 475 in Burgondie
- and died on Jun. 3, 545 in Monastère St Martin, Tours, France. He
married 2nd Amalaberge de france [Des Hérules].
Amalaberge was born in 466 and died in 508 in Allemagne.
Children of Clovis I de france and Clothilde Ste Clothilde des Burgondes de france [de Bourgogne]
i. 54. Clothaire I Le vieux de france was born in 497 and died on Nov. 10, 561.
Children of Clovis I de france and Amalaberge de france [Des Hérules]
ii. 151. Thierry I D’Austrasie was born in 486 in Metz, Moselle and died in 534 in Metz, Moselle.
- Audoflède d’Ostrogothie [de Francie] was born in 469 and died on May 4, 535. She married Théoderic I Le
Grand Roi des Ostrogoths d’Italie d’Ostrogothie in 492. Théoderic I Le Grand Roi des Ostrogoths d’Italie ,
son of Théodemir d’Ostrogothie and Erelieva d’Ostrogothie [De Tongres], was born in 455 and died on Aug. 30,
526 in Ravenne.
Children of Audoflède d’Ostrogothie [de Francie] and Théoderic I Le Grand Roi des Ostrogoths d’Italie d’Ostrogothie
i. 134. Amalasunte Régente d’Italie d’Ostrogothie was born in 535 in Bolsena and died on an unknown date - Clovis I de france was born in Aug. 466 in Tournai and died on Nov. 27, 511 in Paris, Seine.
- See previous entry for Clovis I de france was born in Aug. 466 in Tournai and died on Nov. 27, 511 in Paris, Seine.
- Audoflède d’Ostrogothie [de Francie] was born in 469 and died on May 4, 535.
- See previous entry for Audoflède d’Ostrogothie [de Francie] was born in 469 and died on May 4, 535.
- Chlodomir II De Worms was born in 490 and died in 532.
- See previous entry for Chlodomir II De Worms was born in 490 and died in 532.
- Wautbert Ier, Comte DE PONTHIEU was born About 490 and died About 538.
- See previous entry for Wautbert Ier, Comte DE PONTHIEU was born About 490 and died About 538.
- Gertrude DE PONTHIEU was born About 500 and died on an unknown date.
- See previous entry for Gertrude DE PONTHIEU was born About 500 and died on an unknown date.
- Richard II de cambrai was born in 510 in Artois and died on an unknown date. He married 1st (Unknown). He married
- 2nd (Unknown).
- Children of Richard II de cambrai
- i. 152. Richariane de Septimanie [de cambrai] was born in 530 in Cambrai and died on an unknown date.
- Ricmer II de Cambrai died in 528. He married 1st (Unknown). He married 2nd (Unknown) in 503.
- Children of Ricmer II de Cambrai
- i. 153. Ragnoara D’Orléans [Des Francs] was born in 505 and died on an unknown date.
- Childéric II de france was born in 651 and died in 674. He married Blichilde de france in 670. Blichilde, daughter
- of Sigisbert III Roi d’Austrasie de france and Immichilde de france [des Burgondes] , was born in 655 and died
- on an unknown date.
- Dagobert II Roi d’Austrasie de france was born in 651 and died in 679. He married 1st Mathilde de francein
- Mathilde was born in 651 and died in 670. He married 2nd Gisèle Princesse Wisigothe de france [de Rhedae]
- in 671 in Rennes-le-Château, Midi. Gisèle Princesse Wisigothe was born in 653 in Rennes-le-Château, Midi and died in 676.
- Children of Dagobert II Roi d’Austrasie de france and Gisèle Princesse Wisigothe de france [de Rhedae]
- i. 154. Sigisbert IV Plant-Ard, “Rejeton” Ardent Prince – Ermite Comte de Rhedea de Rhedae was born in
- 676 in Rennes-le-Château, Midi and died in 758 in Rennes-le-Château, Midi.
- Berswinthe d’Alsace [de Bourgogne] was born in 653 in Bourgogne and died in 690 in Alsace. She married
- Aldaric Etichon d’Alsace. Aldaric Etichon was born in 645 in Alsace and died on Feb. 26, 690 in Alsace.
- Blichilde de france was born in 655 and died on an unknown date. She married Childéric II de france in 670.
- Childéric II, son of Clovis II de Neustrie and Bathilde de Neustrie [D’Ascanie] , was born in 651 and died in 674.
- Dagobert II Roi d’Austrasie de france was born in 651 and died in 679.
- See previous entry for Dagobert II Roi d’Austrasie de france was born in 651 and died in 679.
- Berswinthe d’Alsace [de Bourgogne] was born in 653 in Bourgogne and died in 690 in Alsace.
- See previous entry for Berswinthe d’Alsace [de Bourgogne] was born in 653 in Bourgogne and died in 690 in Alsace.
- Blichilde de france was born in 655 and died on an unknown date.
- See previous entry for Blichilde de france was born in 655 and died on an unknown date.
- 23rd Generation (Great(20)-grandchildren)
- Crotochielde d’Ardennes [d’Ostrogothie] was born in 526 and died on an unknown date. She married Brunulphe
- Comte d’Ardennes d’Ardennes in 543 in Montdidier. Brunulphe Comte d’Ardennes, son of Wautbert Ier,
- Comte DE PONTHIEU and Lucile DE PONTHIEU [D’ORIENT], was born in 522 in Ardennes and died in 563 in
- Ardennes.
- Children of Crotochielde d’Ardennes [d’Ostrogothie] and Brunulphe Comte d’Ardennes d’Ardennes
- i. 155. Frédégonde de Neustrie [d’Ardennes] was born in 545 in Montdidier and died in 596 in Paris, Seine.
- ii. 156. Brunulphe II d’Ardennes was born in 560 in Ardennes and died in 618.
- Waubert II, Comte DE HAINAUT was born About 520 and died About 575. He married Amalaberge DE
- HAINAUT [DE THURINGE] About 556. Amalaberge was born About 535 in ALTENBURG, ALLEMAGNE and died About
- 615 in METZ, FRANCE.
- Brunulphe Comte d’Ardennes d’Ardennes was born in 522 in Ardennes and died in 563 in Ardennes. He married
- Crotochielde d’Ardennes [d’Ostrogothie] in 543 in Montdidier. Crotochielde, daughter of Uthéric d’Ostrogothie
- and Amalasunte Régente d’Italie d’Ostrogothie , was born in 526 and died on an unknown date.
- Children of Brunulphe Comte d’Ardennes d’Ardennes and Crotochielde d’Ardennes [d’Ostrogothie]
- i. 155. Frédégonde de Neustrie [d’Ardennes] was born in 545 in Montdidier and died in 596 in Paris, Seine.
- ii. 156. Brunulphe II d’Ardennes was born in 560 in Ardennes and died in 618.
- Ingund de france [de Thuringe] was born in 510 and died in 536. She married Clothaire I Le vieux de france in
- Clothaire I Le vieux, son of Clovis I de france and Clothilde Ste Clothilde des Burgondes de france [de
- Bourgogne], was born in 497 and died on Nov. 10, 561.
- Children of Ingund de france [de Thuringe] and Clothaire I Le vieux de france
- i. 74. Gonthaire de neustrie was born in 519 and died in 561 in Neustrie.
- ii. 75. Caribert I de Paris was born in 520 and died on May 7, 567 in Paris, Seine.
- iii. 76. Sigebert I de france was born in 535 and died in 575 in Austrasie.
- iv. 77. Chilpéric I de Neustrie was born in 537 and died on Oct. 1, 584 in Chelles
- Clothaire I Le vieux de france was born in 497 and died on Nov. 10, 561.
- See previous entry for Clothaire I Le vieux de france was born in 497 and died on Nov. 10, 561.
- Thierry I D’Austrasie was born in 486 in Metz, Moselle and died in 534 in Metz, Moselle. He married 1st Eustère
- D’Austrasie [De Wisigothie]. Eustère was born in 494 in Toulouse, France and died in 521 in Toulouse, France. He
- married 2nd Suavégothe D’Austrasie [De Burgondie]. Suavégothe, daughter of Sigismond II De Burgondie and
- Theudicote De Burgondie [D’Ostrogothie], was born in 504 in Lyon, Rhône and died in 554 in Metz, Moselle.
- Amalasunte Régente d’Italie d’Ostrogothie was born in 535 in Bolsena and died on an unknown date.
- See previous entry for Amalasunte Régente d’Italie d’Ostrogothie was born in 535 in Bolsena and died on an unknown
- date.
- Richariane de Septimanie [de cambrai] was born in 530 in Cambrai and died on an unknown date. She married
- Aedalric Pelles de Septimanie . Aedalric Pelles, son of Wilibald Pellam Pierre Duc Pierre de Lorraine dans
- la Chanson de Geste de Septimanie,de Lorraine,de Burgondie , was born in 530 in Septimanie and died on an
- unknown date.
- Children of Richariane de Septimanie [de cambrai] and Aedalric Pelles de Septimanie
- i. 90. Elyezer de Septimanie was born in 560 in Septimanie and died on an unknown date.
- ii. 91. Althée de Burgondie was born in 560 in Bourgogne and died in 587 in Bourgogne.
- iii. 92. Elaine des Burgondes del acqs [de Septimanie] was born in 565 in Septimanie and died Before 604 in
- Septimanie.
- Ragnoara D’Orléans [Des Francs] was born in 505 and died on an unknown date. She married Pastor D’Orléans
- in 534 in Orléans. Pastor was born in 515 in Orléans and died on an unknown date.
- Children of Ragnoara D’Orléans [Des Francs] and Pastor D’Orléans
- i. 157. Austregilde de Burgondie [D’Orléans] was born in 540 and died on an unknown date.
- Sigisbert IV Plant-Ard, “Rejeton” Ardent Prince – Ermite Comte de Rhedae was born in 676
- in Rennes-le-Château, Midi and died in 758 in Rennes-le-Château, Midi.
- Children of Sigisbert IV Plant-Ard, “Rejeton” Ardent Prince – Ermite Comte de Rhedea de Rhedae
- i. 158. Sigisbert V 2ème Prince -Ermite de Rhedae was born in 695 in Rennes-le-Château, Midi and died in 768 in
- Rennes-le-Château, Mid
- Frédégonde de Neustrie [d’Ardennes] was born in 545 in Montdidier and died in 596 in Paris, Seine. She married
- Chilpéric I de Neustrie in 568 in Paris, Seine. Chilpéric I, son of Clothaire I Le vieux de france and Ingund de
- france [de Thuringe], was born in 537 and died on Oct. 1, 584 in Chelles.
- Children of Frédégonde de Neustrie [d’Ardennes] and Chilpéric I de Neustrie
- i. 88. Clothaire II de france was born in Jun. 584 and died on Oct. 25, 628.
- Brunulphe II d’Ardennes was born in 560 in Ardennes and died in 618.
- Frédégonde de Neustrie [d’Ardennes] was born in 545 in Montdidier and died in 596 in Paris, Seine.
- See previous entry for Frédégonde de Neustrie [d’Ardennes] was born in 545 in Montdidier and died in 596 in Paris,
- Seine.
- Brunulphe II d’Ardennes was born in 560 in Ardennes and died in 618.
- See previous entry for Brunulphe II d’Ardennes was born in 560 in Ardennes and died in 618.
- Gonthaire de neustrie was born in 519 and died in 561 in Neustrie.
- See previous entry for Gonthaire de neustrie was born in 519 and died in 561 in Neustrie.
- Caribert I de Paris was born in 520 and died on May 7, 567 in Paris, Seine.
- See previous entry for Caribert I de Paris was born in 520 and died on May 7, 567 in Paris, Seine.
- Sigebert I de france was born in 535 and died in 575 in Austrasie.
- See previous entry for Sigebert I de france was born in 535 and died in 575 in Austrasie.
- Chilpéric I de Neustrie was born in 537 and died on Oct. 1, 584 in Chelles.
- See previous entry for Chilpéric I de Neustrie was born in 537 and died on Oct. 1, 584 in Chelles.
- Elyezer de Septimanie was born in 560 in Septimanie and died on an unknown date.
- See previous entry for Elyezer de Septimanie was born in 560 in Septimanie and died on an unknown date.
- Althée de Burgondie was born in 560 in Bourgogne and died in 587 in Bourgogne.
- See previous entry for Althée de Burgondie was born in 560 in Bourgogne and died in 587 in Bourgogne.
- Elaine des Burgondes del acqs [de Septimanie] was born in 565 in Septimanie and died Before 604 in Septimanie.
- See previous entry for Elaine des Burgondes del acqs [de Septimanie] was born in 565 in Septimanie and died Before
- 604 in Septimanie.
- Austregilde de Burgondie [D’Orléans] was born in 540 and died on an unknown date. She married Betton de
- Burgondie in 554. Betton was born in 525 and died on an unknown date.
Children of Austregilde de Burgondie [D’Orléans] and Betton de Burgondie
i. 159. Richomer de Burgondie was born in 555 and died on an unknown date.
- Sigisbert V 2ème Prince -Ermite de Rhedae was born in 695 in Rennes-le-Château, Midi and died in 768 in
Rennes-le-Château, Midi. - Clothaire II de france was born in Jun. 584 and died on Oct. 25, 628.
- See previous entry for Clothaire II de france was born in Jun. 584 and died on Oct. 25, 628.
- Richomer de Burgondie was born in 555 and died on an unknown date. He married Gertrude de Burgondie
- [d’hamage] in 589. Gertrude, daughter of Théodebald De Bavière, was born in 570 and died in Dec. 649.
- Children of Richomer de Burgondie and Gertrude de Burgondie [d’hamage]
- i. 111. Bérétrude de france [de Burgondie] was born in 590 and died in 618.
- Bérétrude de france [de Burgondie] was born in 590 and died in 618
Here’s my genetic genealogy connection
Chilperic DeBurgundy 450-493
22nd great-grandfather
Agilofinginne Cologne DeBurgundy*
Daughter of Chilperic DeBurgundy
Clothaire I France NaN-
Son of Agilofinginne Cologne DeBurgundy*
Dagobert I Austrasia
Son of Clothaire I France
Sigebert Austrasia
Son of Dagobert I Austrasia
Dagobert Austrasia NaN-
Son of Sigebert Austrasia
Sigebert IV Comte De Razes -NaN
Son of Dagobert Austrasia
Dagobert Young Merovingian Austrasia 651-679
Son of Sigebert IV Comte De Razes
Sigebert Comte Razes Merovingian 1445-1495
Son of Dagobert Young Merovingian Austrasia
Sigebert IV Compte Rynzza Ryzza de Razes Iv 1475-1520
Son of Sigebert Comte Razes Merovingian
William Kythin 1500-1561
Son of Sigebert IV Compte Rynzza Ryzza de Razes Iv
Isabell Constance Pateson 1512-1573
Daughter of William Kythin
Sir Robert Webster 1550-1609
Son of Isabell Constance Pateson
William Webster 1580-1652
Son of Sir Robert Webster
Lady Joyce Hester Webster Bell 1629-1702
Daughter of William Webster
Robert Bell 1683-1738
Son of Lady Joyce Hester Webster Bell
George W Bell 1718-1792
Son of Robert Bell
Hezekiah Bell 1758-1803
Son of George W Bell
Perthena “Wena” “Theney” Bell 1785-1847
Daughter of Hezekiah Bell
Martha Anna Williams (Morgan) 1812-1899
Daughter of Perthena “Wena” “Theney” Bell
Martha Henrietta Warner 1842-1945
Daughter of Martha Anna Williams (Morgan)